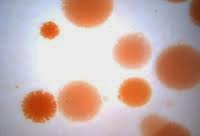
Bakteri Halofilik

Jumlah dan Morfologi Bakteri Halofilik pada Telur Asin Komersial di
Telur Asin dan Bakteri Halofilik
Bakteri halofilik merupakan mikroorganisme yang dapat hidup dan berkembang biak di lingkungan dengan kadar garam yang tinggi. Salah satu tempat di mana bakteri halofilik dapat ditemukan adalah pada telur asin komersial. Telur asin merupakan salah satu produk olahan makanan yang telah melalui proses pengawetan dengan menggunakan garam.

Apa Itu Bakteri Halofilik?
Bakteri halofilik merupakan jenis bakteri yang memiliki kemampuan untuk bertahan hidup dan berkembang biak dalam lingkungan dengan kadar garam yang tinggi, biasanya di atas 10%. Mereka mampu mengatasi tekanan osmotik yang tinggi dan berkembang biak dengan baik dalam kondisi lingkungan yang mengandung garam.
Ciri-ciri Bakteri Halofilik
Bakteri halofilik memiliki beberapa ciri-ciri yang membedakannya dengan jenis bakteri lainnya. Ciri-ciri tersebut antara lain:
- Mampu hidup dan berkembang biak dalam lingkungan yang mengandung garam dengan konsentrasi tinggi.
- Mempunyai adaptasi terhadap tekanan osmotik yang tinggi.
- Mampu membentuk pigmen tertentu yang memberikan warna khas pada koloninya.
- Memiliki morfologi yang khas, seperti bentuk bulat atau batang, dan kadang-kadang membentuk rantai atau tumpukan sel yang disebut sebagai tetrads.
- Beberapa jenis bakteri halofilik juga mampu menghasilkan enzim yang dapat digunakan dalam proses industri.
Klasifikasi Bakteri Halofilik
Berdasarkan klasifikasi ilmiah, bakteri halofilik termasuk ke dalam kelompok Archaea. Archaea merupakan salah satu dari tiga domain kehidupan yang ada di Bumi, selain Bacteria dan Eukarya. Archaea memiliki perbedaan dalam struktur dan proses seluler dengan Bacteria dan Eukarya. Ada beberapa jenis bakteri halofilik yang telah diidentifikasi dan diklasifikasikan, termasuk:
- Halobacterium
- Haloarcula
- Halogeometricum
- Halorubrum
- Natrialba
Jenis-jenis Bakteri Halofilik
Bakteri halofilik dapat dibagi menjadi beberapa jenis berdasarkan sifat dan karakteristiknya. Beberapa jenis bakteri halofilik yang telah diidentifikasi antara lain:
- Halobacterium salinarium: Bakteri ini ditemukan pada lingkungan yang memiliki konsentrasi garam yang tinggi seperti Danau Matano di Indonesia.
- Haloarcula marismortui: Bakteri ini ditemukan pada lingkungan dengan kadar garam yang tinggi, seperti Laut Matano di Indonesia.
- Halogeometricum borinquense: Bakteri ini ditemukan pada lingkungan seperti Danau Matano di Indonesia.
- Halorubrum saccharovorum: Bakteri ini ditemukan pada lingkungan dengan kadar garam yang tinggi, seperti Laut Matano di Indonesia.
- Natrialba asiatica: Bakteri ini ditemukan pada lingkungan yang memiliki konsentrasi garam yang tinggi seperti Danau Matano di Indonesia.

Cara Berkembang Biak Bakteri Halofilik
Bakteri halofilik dapat berkembang biak melalui dua cara, yaitu:
- Pembelahan Biner: Bakteri halofilik dapat mengalami pembelahan biner, yaitu membelah menjadi dua sel yang identik. Proses ini berlangsung secara cepat dan membantu dalam proliferasi populasi bakteri halofilik dalam lingkungan dengan kadar garam yang tinggi.
- Pembentukan Spora: Beberapa jenis bakteri halofilik juga dapat membentuk spora sebagai mekanisme adaptasi terhadap kondisi lingkungan yang tidak menguntungkan. Spora ini adalah struktur resisten yang memungkinkan bakteri halofilik bertahan hidup dalam jangka waktu yang lama hingga kondisi lingkungan menjadi lebih baik.
Contoh Bakteri Halofilik pada Telur Asin Komersial
Penelitian yang dilakukan oleh Ahmad Fauzi (2021) bertujuan untuk mengidentifikasi jenis dan morfologi bakteri halofilik pada telur asin komersial. Dalam penelitian ini, dilakukan isolasi dan identifikasi bakteri halofilik dari sampel telur asin komersial yang diperoleh dari beberapa pasar di Indonesia.
Hasil penelitian menunjukkan bahwa terdapat beberapa jenis bakteri halofilik pada telur asin komersial, antara lain:
- Haloarcula
- Halobacterium
- Halogeometricum
- Halorubrum
- Natrialba
Morfologi bakteri halofilik pada telur asin komersial juga beragam, terdiri dari bentuk bulat atau batang, dan dalam beberapa kasus membentuk rantai atau tumpukan sel yang disebut sebagai tetrads.
Penelitian ini memberikan gambaran mengenai jumlah dan morfologi bakteri halofilik pada telur asin komersial di Indonesia. Mengetahui jenis dan morfologi bakteri halofilik pada telur asin komersial penting dalam memahami keamanan pangan dan mengidentifikasi potensi risiko kesehatan yang terkait dengan telur asin.
Telur asin komersial yang terkontaminasi oleh bakteri halofilik dapat menjadi sumber infeksi bagi manusia jika dikonsumsi secara mentah atau tidak matang. Oleh karena itu, penting untuk memastikan keamanan dan kualitas telur asin melalui proses produksi, penanganan, dan penyimpanan yang baik.
Kesimpulan
Bakteri halofilik merupakan jenis bakteri yang memiliki adaptasi terhadap lingkungan dengan kadar garam yang tinggi. Mereka memiliki kemampuan untuk hidup dan berkembang biak dalam kondisi yang ekstrem seperti pada telur asin komersial. Bakteri halofilik memiliki ciri-ciri dan morfologi khas yang membedakannya dengan jenis bakteri lainnya.
Telur asin komersial dapat terkontaminasi oleh berbagai jenis bakteri halofilik, seperti Haloarcula, Halobacterium, Halogeometricum, Halorubrum, dan Natrialba. Keberadaan bakteri halofilik pada telur asin komersial dapat memberikan potensi risiko kesehatan jika tidak ditangani dengan baik.
Penelitian mengenai jumlah dan morfologi bakteri halofilik pada telur asin komersial penting untuk memahami keamanan pangan dan menjaga kualitas produk. Diperlukan upaya dalam proses produksi, penanganan, dan penyimpanan telur asin untuk meminimalkan kontaminasi bakteri halofilik dan risiko kesehatan yang terkait.
Menjaga kebersihan dan higienitas produk, serta melakukan pengawasan dan pengujian kualitas secara rutin, merupakan langkah penting dalam menjaga keamanan dan kualitas telur asin komersial yang dikonsumsi oleh masyarakat.
Sumber data:
- http://repository.unhas.ac.id/12635/1/I11116059_skripsi_05-11-2021 cover1.png
- http://4.bp.blogspot.com/-bqYC6qgAu68/VNtfYOJ_BSI/AAAAAAAAAHk/m8wtl70sDJs/s1600/Halofilik.jpeg
- https://i1.rgstatic.net/publication/347562267_Produksi_dan_Optimasi_Biosurfaktan_dari_Bakteri_Halofilik_Chromohalobacter_japonicus_BK-AB18/links/5fee194da6fdccdcb81e8c40/largepreview.png
- https://kelautan.fpik.undip.ac.id/wp-content/uploads/2020/11/megong-980×441.jpg


